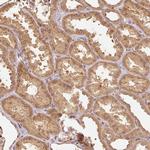
FUT8 Antibody in Immunohistochemistry (Paraffin) (IHC (P))

Search
Invitrogen
FUT8 Polyclonal Antibody
{{$productOrderCtrl.translations['antibody.pdp.commerceCard.promotion.promotions']}}
{{$productOrderCtrl.translations['antibody.pdp.commerceCard.promotion.viewpromo']}}
{{$productOrderCtrl.translations['antibody.pdp.commerceCard.promotion.promocode']}}: {{promo.promoCode}} {{promo.promoTitle}} {{promo.promoDescription}}. {{$productOrderCtrl.translations['antibody.pdp.commerceCard.promotion.learnmore']}}
产品信息
PA5-60353
宿主/亚型
分类
类型
抗原
偶联物
形式
浓度
规格
保存条件
运输条件
RRID
产品详细信息
Immunogen sequence: WSGEVKDKNV QVVELPIVDS LHPRPPYLPL AVPEDLADRL VRVHGDPAVW WVSQFVKYLI RPQPWLEKEI EEATKKLGFK HPVIGVHVRR TD
Highest antigen sequence identity to the following orthologs: Mouse - 97%, Rat - 98%.
靶标信息
Alpha-(1,6)-fucosyltransferase (FUT8) is a gene located on chromosome 14q23.3, encoding an enzyme that catalyzes the addition of fucose to N-glycans via alpha-1,6-linkage. This fucosylation is important in modifying glycoproteins, influencing their function, stability, and interactions within biological systems. FUT8 activity is crucial in various physiological processes, including immune regulation, cell signaling, and development. Aberrant fucosylation patterns, due to altered FUT8 expression, have been associated with pathological conditions such as cancer and inflammatory diseases. In oncology, FUT8-mediated core fucosylation of glycoproteins is linked to tumor progression, metastasis, and therapeutic resistance, making it a potential biomarker for cancer diagnosis and prognosis. Additionally, FUT8's role in immune function highlights its involvement in cellular communication and homeostasis, offering insights into therapeutic strategies aimed at modulating glycosylation pathways to address disease states.
仅用于科研。不用于诊断过程。未经明确授权不得转售。